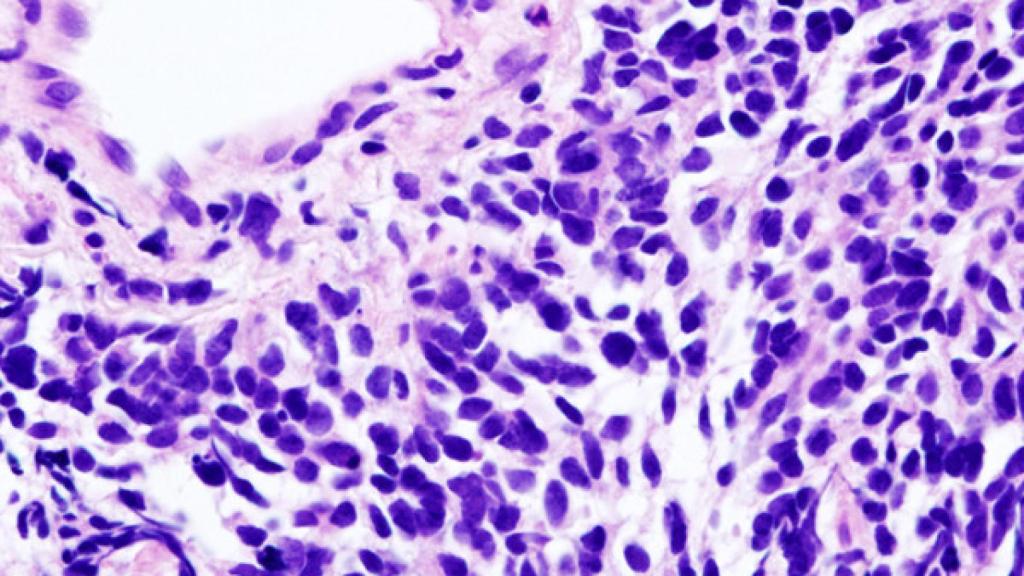
Castilla y León

Castilla y León
Investigadores de la Universidad de Granada (UGR) han descubierto cómo una proteína llamada placofilina-1(PKP1) actúa promoviendo el desarrollo en cáncer de pulmón. Hasta ahora, las funciones de la placofilina-1 en el cáncer eran poco conocidas, pero se sabían bien las funciones que desarrolla el producto de este gen en la piel, donde forma parte de unas estructuras llamadas desmosomas, que sirven para aportar resistencia y cohesión de la piel.
La importancia de los desmosomas es bien sabida porque las personas que tienen alteradas estas estructuras presentan problemas severos en la piel. De hecho, las personas con mutaciones en PKP1 desarrollan una enfermedad llamada epidermólisis ampollosa simple, caracterizada por tener la piel muy sensible y sufrir con extrema facilidad erosiones y ampollas.
“Se desconocía completamente por qué esta proteína, que tiene una función importante en la piel, aumentaba sus niveles en cáncer de pulmón” indica Pedro P. Medina Vico, investigador del departamento de Bioquímica y Biología Molecular I de la Universidad de Granada y director del grupo de investigación que ha realizado íntegramente las investigaciones en el centro Pfizer-Universidad de Granada-Junta de Andalucía de Genómica e Investigación Oncológica (GENYO).
“En primer lugar, nosotros observamos que PKP1 se trataba de una de las proteínas que mayor aumentaba sus niveles en los pacientes de cáncer de pulmón. Y era extraño observar que una proteína propia de la piel se expresara tumores de pulmón”, señala Laura Boyero Corral, una de las autoras principales del estudio.
“Pero además era una incógnita por qué una proteína que colabora en mantener las células unidas aumenta sus niveles en los procesos tumorales, que tienden a adquirir precisamente estrategias de dispersión, para generar lo que se denomina metástasis”, comenta Joel Martín Padrón, otro de los autores del estudio, que forma parte de la tesis doctoral que está realizando en la UGR.
“Tras analizar nuestros resultados y lo que se conocía hasta ese momento de PKP1, pensamos que podía estar regulando la actividad de un gen denominado MYC cuyo producto es muy conocido en cáncer, ya que actúa reprogramando la maquinaria de la célula para desarrollar tumores. Inmediatamente, diseñamos una serie de experimentos para probar esta hipótesis. Cuando obtuvimos los resultados de tales experimentos, concluimos con claridad que así era”, concluye Pedro Medina.
En la publicación científica, los autores muestran un vídeo donde se observa que células derivadas de cáncer de pulmón empiezan a morir cuando se les impide la producción de PKP1, mientras que las que producen PKP1 continúan creciendo.
El presente trabajo abre la puerta al desarrollo de nuevas estrategias antitumorales. Se conoce desde hace tiempo que la inhibición de la actividad de MYC, un gen que promueve el desarrollo de tumores, podría ser importante como terapia del cáncer. Sin embargo, los intentos para encontrar inhibidores de MYC, por la naturaleza de esta molécula, han tenido poco éxito hasta ahora.
“Hemos demostrado que las células que presentan el producto de PKP1 producen tumores en modelos pre-clínicos, y cuando eliminamos este gen mediante las novedosas técnicas de edición génica (CRISPR-Cas), las células son incapaces de producir tumores, por lo que la inhibición de PKP1 podría ser de utilidad como terapia contra el cáncer” indica Pedro Medina.
En la financiación de este trabajo ha participado la Asociación Española Contra el Cáncer (AECC) y la International Association for the Study of Lung Cancer (IASLC). El estudio ha sido publicado recientemente en Oncogene.



